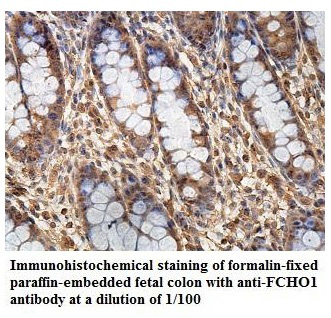

FCHO1 Antibody, FITC conjugated
MBS7107877
Product group Antibodies
Overview
- SupplierMyBioSource
- Product NameFCHO1 Antibody, FITC conjugated
- Delivery Days Customer16
- CertificationResearch Use Only
- ConjugateFITC
- Estimated Purity>95%, Protein G purified
- IsotypeIgG
- Storage Instruction-20°C or -80°C
- UNSPSC12352203